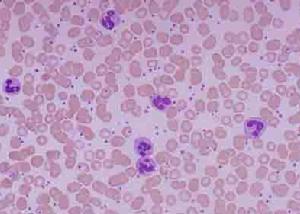
先天性白細胞顆粒異常綜合徵

概述
先天性白細胞顆粒異常綜合徵又稱契-東綜合徵,是Chediak、Higashi分別於1952年和1954年發現,故名Chediak-Higashi綜合徵。
流行病學:1943年首次發現本病,1952年Chédiak和1954年Higashi做了進一步描寫,並命名為Chédiak-Higashi綜合徵。1966年發現引起本病的突變基因CHS1。
病因
白細胞
白細胞 疾病病理
 透射電子顯微鏡
透射電子顯微鏡 中性粒細胞吞噬功能正常吞噬後釋放過氧化氫也正常但對某些細菌殺死作用延遲。由於溶菌酶的釋放與進入,使吞噬小體功能不全或無效。現認為契-東綜合徵患者細胞內cAMP含量增加,而cGMP含量下降致中性粒細胞功能缺陷。
分子生物學證實由於編碼溶酶體運輸調節蛋白的CHS基因突變導致多組織中溶酶體顆粒形態形成缺陷。屬白細胞識別和吞噬功能異常性疾病。
組織病理
電鏡下可見黑素細胞內有大而形態不規則的巨黑素體,互相融合,最大的顆粒發生變性、空泡化。黑素細胞內也含有正常的黑素體,並轉移至角質形成細胞內,在角質形成細胞內,這些黑素體並不分散,卻包裝於大的吞噬溶酶體內。毛髮內也有這種大而有膜的吞噬溶酶體。具體如下圖:
 先天性白細胞顆粒異常綜合徵
先天性白細胞顆粒異常綜合徵 1.早幼粒細胞漿中有大量空泡。
2.中性粒細胞漿中黃紅色橢圓形或圓形嗜酸異常顆粒約10個。
3.異型淋巴細胞漿中有3個紫紅色異常顆粒。
4~6.早幼粒細胞漿中有粉紅色或紫紅色異常顆粒,其中4、5異常顆粒周圍有透光帶。
7.異型淋巴細胞漿中有2個紫紅色異常顆粒。
8.淋巴細胞漿中有紫紅色異常顆粒,周圍有透光帶。
9.嗜酸晚幼粒細胞漿中有數個外形不規則的黃紅色異常顆粒。
臨床表現
 白化症
白化症 由於白細胞異常,常發生皮膚和呼吸道細菌性和病毒性感染,皮膚感染程度輕重不一,由表淺性膿皮病至深在性膿腫、潰瘍。但常因嚴重感染於發育前死亡。患者體質虛弱,發熱、多汗、晚期常有淋巴結肝脾腫大,部分患者並發惡性淋巴瘤或因血小板減少出血死亡。由於血小板減少而致出血傾向,可為輕微的皮膚瘀斑,也可發生嚴重的出血。常有肝脾腫大和全血細胞減少。
神經系統表現為進行性智力低下、驚厥、腦神經麻痹和進行性周圍神經病健康搜尋包括震顫、肌萎縮、無力、深腱反射減弱、步態不穩和足下垂。
大約85%的病例發展為所謂的“快速進展期”表現為發熱黃疸、假膜性口腔炎肝脾和淋巴結腫大,全血象下降和出血。淋巴組織增生伴全身性淋巴細胞浸潤相似於淋巴瘤,但並非惡性腫瘤,更接近於家族性吞噬紅細胞性淋巴組織細胞增生症或病毒誘導的噬血細胞綜合徵。
併發症:
可並發高熱、肝脾和淋巴結腫大,嚴重胃腸道出血,溶血性貧血及低丙種球蛋白血症等情況此時應考慮為加速期是疾病惡化症狀預後不良。
診斷
 白癜風
白癜風 鑑別診斷:
與假CHS鑑別,所謂“假Chédiak-Higashi異常”是指粒細胞性白血病偶爾伴有細胞質巨大顆粒,應與本病鑑別。
與白癜風鑑別
1.白癜風為後天性疾病,發病較晚,先天性白細胞顆粒異常綜合徵屬遺傳性疾病,發病較早。
2.白癜風白斑形態大小不一,邊界色素加深,先天性白細胞顆粒異常綜合徵呈花斑狀色素減少,伴毛髮稀少,灰白或淺黃及虹膜半透明症狀。
3.白癜風黑素細胞減少或消失,先天性白細胞顆粒異常綜合徵發現巨黑素體,白細胞異常。
疾病檢查
 細胞器
細胞器 1.細胞學檢查特徵性表現為細胞內巨大細胞器(包涵體、溶酶體和黑色素體)。包涵體存在於所有顆粒性細胞中,中性粒細胞、嗜酸細胞和嗜鹼細胞內顆粒形態不規則,藍色或灰藍色PAS染色陽性而淋巴細胞內的巨大顆粒呈圓形或卵圓形,嗜天青色。患兒黑色素細胞內充滿黑色素體,主要分布於細胞核周圍。骨髓粒細胞充滿空泡和異常顆粒,偶爾空泡非常巨大,PAS陽性和酸性磷酸酶陽性包涵體。細胞質內增大的顆粒還見於單核細胞紅細胞前體、組織細胞、血小板、神經元、腎小管上皮細胞和成纖維細胞。光學和電子顯微鏡發現皮膚和眼部黑色素細胞內巨大的異常黑色素體,由於未成熟的黑色素體與溶酶體融合,使黑色素體過早破壞,導致黑色素缺乏發生眼皮膚白化症。
2.免疫學檢查中性粒細胞和單核細胞的趨化和細胞內殺菌功能降低,而吞噬功能正常。NK細胞數和與靶細胞結合的能力正常但其殺傷功能缺乏。抗體依賴性細胞殺傷功能也明顯下降γδT細胞數量相對增多細胞毒性T細胞的殺傷功能下降。B細胞功能正常。
3.基因分析了解CHS1基因突變還未成為一種常規診斷手段。
4.外周血進行性貧血、中性粒細胞和血小板減少,因為中性粒細胞易破壞,血清溶菌酶活性增高。中性粒細胞(包括早及中幼嗜酸、嗜鹼粒細胞)的細胞質中含有過氧化物酶陽性顆粒和嗜天青Dohle小體樣顆粒,大小不一,直徑2-5μm。淋巴及單核細胞中也有此顆粒。
5.中性粒細胞功能缺陷:遊走性和趨化性功能不全,殺菌力低下吞噬功能正常。中性粒細胞環核苷酸測定:cAMP含量顯著升高(7~8倍於正常人),cGMP含量降低。血清溶菌酶含量升高
6.骨髓象細胞中有空泡,偶見被吞噬異物,有的胞核較固縮。
7.細胞免疫、免疫球蛋白和補體均正常。
其它輔助檢查:
腦CT和MRI顯示播散性腦和脊髓萎縮電生理研究表明神經纖維傳導電位顯著受損,肌電圖為正常或提示神經元受損。組織化學和電子顯微鏡發現周圍神經組織神經鞘膜細胞內特徵性巨大顆粒。肌肉組織呈神經源性萎縮伴有異常的酸性磷酸酶陽性顆粒和自飲性空泡。
治療
主要應積極控制感染早期發現及治療是關鍵,預防性用藥有害而無益。有人曾用長春新鹼和潑尼松治療有效但尚無成熟經驗。脾功能亢進時可考慮脾切除術,但要嚴格掌握手術指征,4歲以下小兒若行脾切除術術後應給苄星青黴素(長效青黴素),每月1次,以預防肺炎雙球菌腦膜炎。維生素C和環核苷酸可改進患者粒細胞功能。必要時輸中性粒細胞或鮮血異基因骨髓移植可考慮施行。
預後及預防
 神經系統
神經系統 多數患兒於10歲內死亡66%於3.1歲時死亡,死亡原因為化膿性感染、出血和“加速期”的併發症大約15%的病人為CHS1基因錯義突變,臨床症狀輕微,能長期存活,但其神經系統症狀使預後也相對較差極少數無義突變的純合子的症狀也可能較輕,其原因還不清楚。
預防:
1.孕婦保健已知一些免疫缺陷病的發生與胚胎期發育不良密切相關。如果孕婦受到放射線照射、接受某些化學藥物的治療或發生病毒感染(特別是風疹病毒感染)等則可損傷胎兒的免疫系統,特別是在孕早期可使包括免疫系統在內的多系統受累故加強孕婦保健特別是孕早期保健十分重要。孕婦應避免接受放射線慎用一些化學藥物健康搜尋,注射風疹疫苗等,儘可能防止病毒感染。還要使孕婦加強營養,及時治療一些慢性病。
2.遺傳諮詢及家族調查雖然大多數疾病不能確定遺傳方式,但對確定了遺傳方式的疾病進行遺傳諮詢是很有價值的。如果成人有遺傳性免疫缺陷病將提供他們子女的發育危險性;如果一個小孩患有常染色體隱性遺傳或性聯免疫缺陷病,就要告訴父母親他們下一胎孩子患病的可能性有多大。對於抗體或補體缺陷患者的直系家屬應檢查抗體和補體水平以確定家族患病方式對於某些已能進行基因定位鶒的疾病,如慢性肉芽腫病,患者父母、同胞兄妹及其子女均應做定位基因檢測,如果發現有患者,同樣應在他(她)的家庭成員中進行檢查患者的子女應在出生開始就仔細觀察有無疾病發生。
3.產前診斷某些免疫缺陷病能進行產前診斷,如培養的羊水細胞酶學檢查可診斷腺苷脫氨酶缺乏症、核苷磷酸化酶缺乏症及某些聯合免疫缺陷病;胎兒血細胞免疫學檢測可診斷CGD、X-聯無丙種球蛋白血症、嚴重聯合免疫缺陷病,從而中止妊娠,防止患兒的出生。Chédiak-Higashi綜合徵死亡率較高,應研究早期準確診斷的方法,及早給予特異性治療和提供遺傳諮詢(產前診斷甚至宮內治療)非常重要。
